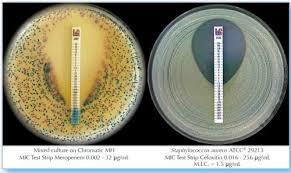
माइक टेस्ट स्ट्रिप्स एमिकासिन 0.016 A 256 (Fda क्लियर)

माइक टेस्ट स्ट्रिप्स एमिकासिन 0.016 A 256 (Fda क्लियर)
प्राइस: 4000.00 - 25000.00 INR
नवीनतम कीमत पता करें
स्टॉक में
| टाइप करें | Antimicrobial Susceptibility Test Strips |
| रासायनिक नाम | Amikacin Dihydrate (impregnated on strip), Amikacin Dihydrate (impregnated on strip) |
| वर्गीकरण | Antibiotic (Aminoglycoside) MIC Test Strip, Antibiotic (Aminoglycoside) MIC Test Strip |
| कैस नं | 37517-28-5 |
| शुद्धता (%) | Test-specific product; not applicable |
विस्तृत जानकारी
| टाइप करें | Antimicrobial Susceptibility Test Strips |
| रासायनिक नाम | Amikacin Dihydrate (impregnated on strip), Amikacin Dihydrate (impregnated on strip) |
| वर्गीकरण | Antibiotic (Aminoglycoside) MIC Test Strip, Antibiotic (Aminoglycoside) MIC Test Strip |
| कैस नं | 37517-28-5 |
| शुद्धता (%) | Test-specific product; not applicable |
| ईआईएनईसीएस नं | 253-497-0 |
| रंग | White with black-printed gradient scale |
| दुसरे नाम | Etest Amikacin; Amikacin MIC Test |
| एच एस कोड | 3822.90.90 |
| दिखावट | Plastic strip with antimicrobial gradient |
| शेप | Flat rectangular strip, Flat rectangular strip |
| भौतिक रूप | Solid plastic strip, Solid plastic strip |
| गंध | Odorless, Odorless |
| विषैला | Not for human consumption; laboratory diagnostic use only, Not for human consumption; laboratory diagnostic use only |
| आण्विक सूत्र | C22H43N5O13·2H2O (for Amikacin Dihydrate) |
| आणविक भार | 585.6 g/mol (Amikacin Dihydrate) |
| स्ट्रक्चरल फॉर्मूला | Not specified on product sheet |
| मेल्टिंग पॉइंट | Not applicable (test strip form) |
| एप्लीकेशन | Determination of Minimum Inhibitory Concentration (MIC) of Amikacin, Determination of Minimum Inhibitory Concentration (MIC) of Amikacin |
| उपयोग | Clinical microbiology laboratory, antimicrobial susceptibility testing |
| स्टोरेज | 2-8°C (store refrigerated), protect from direct light, 2-8°C (store refrigerated), protect from direct light |
| शेल्फ लाइफ | As per manufacturer, generally 3 years from date of production |
| ग्रेड | Diagnostic/Laboratory use, FDA Cleared |
कंपनी का विवरण
सर ग्रुप, 2012 में दिल्ली के दिल्ली में स्थापित, भारत में रासायनिक अभिकर्मक का टॉप आयातक,वितरक,आपूर्तिकर्ता,व्यापार कंपनी है। सर ग्रुप ट्रेड इंडिया के सूचीबद्ध उत्पादों के सत्यापित और विश्वसनीय विक्रेताओं में से एक है। आपूर्ति और व्यापार के अपने व्यापक अनुभव के साथ, सर ग्रुप ने उच्च गुणवत्ता आदि के साथ बाजार में अपने लिए एक प्रतिष्ठित नाम बनाया है। ग्राहक केंद्रित दृष्टिकोण पर ध्यान केंद्रित करते हुए, सर ग्रुप की अखिल भारतीय उपस्थिति है और पूरे देश में एक विशाल उपभोक्ता आधार को पूरा करता है। सर ग्रुप से ट्रेड इंडिया के गुणवत्ता-सुनिश्चित उत्पादों () को थोक में खरीदें।
व्यापार के प्रकार
आयातक, वितरक, आपूर्तिकर्ता, व्यापार कंपनी
कर्मचारी संख्या
25
स्थापना
2012
कार्य दिवस
सोमवार से रविवार
जीएसटी सं
07BXSPD1989H1ZY
Explore in english - MIC TEST STRIPS Amikacin 0.016 – 256 (FDA CLEARED)
विक्रेता विवरण
सर ग्रुप
जीएसटी सं
07BXSPD1989H1ZY
रेटिंग
4
नाम
रामभजन द्विवेदी
पता
प्लाट नो- ड़१७/६३ रोहिणी सेक्टर ३, नियर राम लीला पार्क, दिल्ली, दिल्ली, 110085, भारत
गलत विवरण की रिपोर्ट करें




































